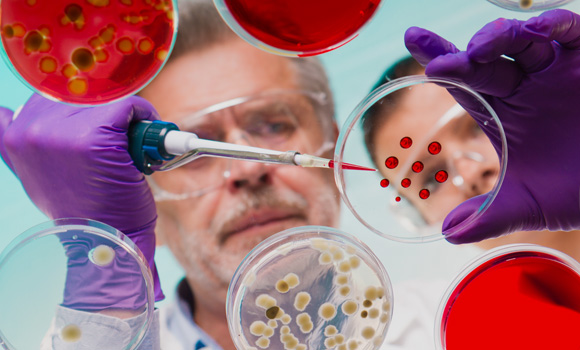

논문컨설팅
통계논문월드
논문컨설팅

경영학 경제학 통계학 마케팅 고객관리 인사 조직론 전략 금융공학 재무 회계학 투자 경영정보시스템(MIS) 예술 경영 의료경영 호텔경영

의학 간호학 보건학 임상병리학

건설환경공학 건축학 기계공학 우주항공공학 조선해양공학 산업공학 재료공학 전기전자공학 컴퓨터공학 화학생물공학 에너지자원공학

수리과학 물리학 천문과학 생물학 컴퓨터과학 화학 지구환경과학 생명과학 유전과학

국어국문학 중어중문학 영어영문학 불어불문학 독어독문학 노어노문학 서어서문학 아시아언어문명학 언어학 국사학 동양사학 서양사학 철학 종교학 미학 고고미술사학

교육학 교육심리 교육상담 교육행정 교육과정 교육사회 교육철학 교육경제 교육측정평가 교육공학 평생교육 교육인류학 국어교육 영어교육 불어교육 독어교육 사회교육 역사교육지리교육 윤리교육 수학교육 물리교육 화학교육 생물교육지구과학교육 체육교육

성악, 작곡(작곡전공, 이론전공) 기악(피아노전공, 현악전공, 관악전공) 국악 동양화 서양화 조소 디자인학(공예) 디자인학(디자인) 패션디자인
식물생산과학 산림과학 농경제사회학 응용생물화학 식품·동물생명공학 바이오시스템·소재학 조경·지역시스템공학 소비자아동학(소비자학전공, 아동가족학전공) 식품영양학 의류학

정치외교학 행정학 경제학 사회학 심리학 지리학 인류학 사회복지학 언론정보학 법학